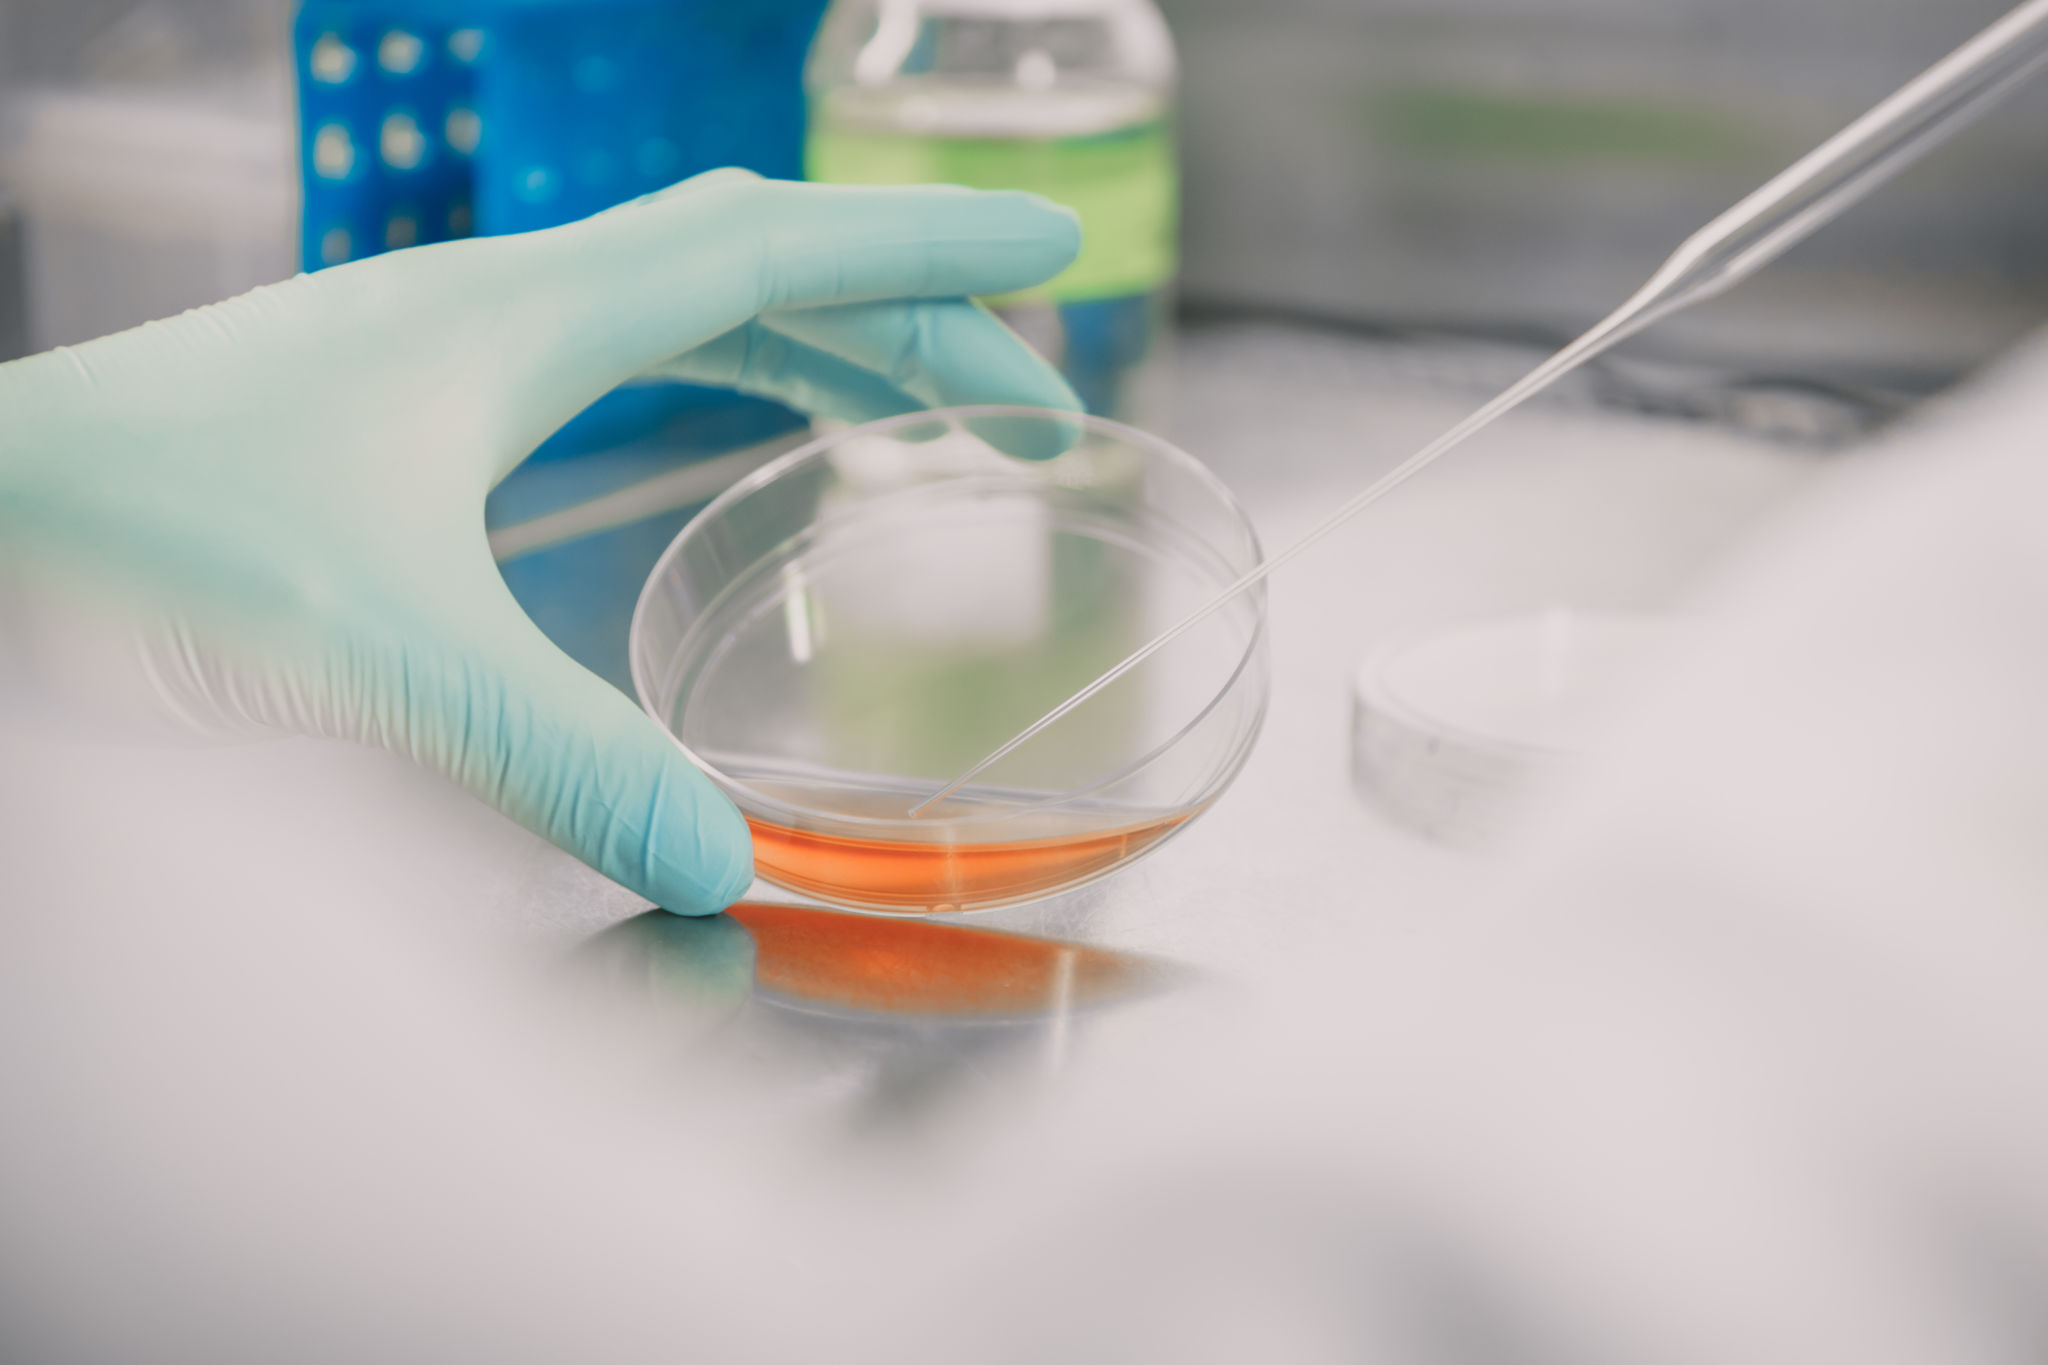

Farmaci – forskning och personal
Aktuella forskningsgrupper vid farmacin (Pharmaceutical Sciences Laboratory):
Biomaterials and Drug Fabrication
Gruppledare: akademiforskare Xiaoju Wang
BioNanoMaterials
Gruppledare: professor Jessica Rosenholm och professor Tapani Viitala
Computer-aided drug design
Gruppledare: äldre universitetslektor Outi Salo-Ahen
Functional Materials for Medicine
Gruppledare: professor Hongbo Zhang
Translational ADME and Pharmacodynamics
Gruppledare: äldre universitetslektor Anne Filppula
Undervisande personal
Jessica Rosenholm, TkD
Professor i farmaci, företrädesvis läkemedelsutveckling, ämnesansvarig
Tapani Viitala, FD
Professor i nya läkemedelsformuleringar (50%, delad med Helsingfors universitet)
Hongbo Zhang, PhD
Professor i farmaceutiska biomaterial
Anne Filppula, FD
Äldre universitetslektor i farmaci, magisterprogramansvarig
Ulla-Mari Parkkisenniemi-Kinnunen, FaD
Äldre universitetslektor i farmaceutisk farmakologi
Outi Salo-Ahen, FaD
Äldre universitetslektor i farmaci, kandidatprogramansvarig
Mirja Palo, PhD
Universitetslektor i farmaci
Anne Eriksson, farmaceut, FM
Universitetslärare
Johan Nyman, DI, FM
Universitetslärare
Äldre forskare
Heidi Koivisto
Business Champion, Comitell project (Business Finland)
Sergej Filippov
Gästprofessor, University of Reading, UK
Yue Ma
Gästprofessor, Jiangsu University, China
Postdoktorala forskare
Ezgi Özliseli
Fadak Howaili
Feika Bian
Jiaqi Yan
Kuldeep Bansal
Mirja Palo
Neeraj Prabhakar
Parthiban Marimuthu
Rawand Abdulrahman
Rajendra Bhadane
Xiaoju Wang
Xiaoyu Xu
Yunru Yu
Özge Karadas
Doktorander
Alaa Mahran, M.Sc.(Pharm.)
Anna Hämäläinen, M.Sc. (Cell Biology)
Anna Slita, M.Sc.(Bio)
Atefeh Saadabadi, M.Sc.
Brandon Garate, M.Sc. (Biotechnology)
Chaoping He, M.Med. (Chinese Materia Medica)
Chen Wang, M.Med. (Surgery)
Chengcheng Li, M. Sc. (Pharm.)
Chengcheng Zhang, M.Sc. (Clinical Medicine)
Chenyu Zong, M.Sc. (Biotechnology)
Chetan Pathak, M.Sc. (Pharm)
Dabao Shang
Dhayakumar Rajan Prakash, M.Sc. (Nano. Med.)
Emel Bakay, M.Sc. (Biomed. Eng.)
Fanny Frejborg, M.Sc.(Drug Discovery & Development)
Farnaz Shokraneh, M.Sc. (Pharm.)
Ida Alanko, M.Sc. (Pharm.Sci)
Jessica Salo, M.Sc. (Biomedical Imaging)
Jinbo Li, M.Sc. (Biotechnology)
Jing Yang, M.Sc. (Pharm.Sci.)
Johan Nyman, M.Sc.(Chem. Eng. & Pharm. Sci.)
Jyoti Verma, M.Pharm.
Kexin Yi, M. Sc. (Pharm.)
Li Wang, M. Sc. (Pharm.)
Lu Fan, M. Sc.
Longxi Wu, M. Sc. (Pharm.)
Masha Bahman, M.Sc. (Biotechnology)
Meixin Ran, M.Sc. (Pharm. Sci.)
Minjie Fan
Oliver Koivisto, M.Sc. (Genetics)
Pengzhen Zhuang, M.Sc. (Mater Sci and Engineer)
Rabia Gulshan, M.Sc. (Pharmaceutics)
Rathna Mathiyalagan, M.Sc.(Chem.)
Sachin Gautam, M.Pharm.(Pharmacology)
Shengyi Wang, M.Sc. (Microbiol.)
Shujun Liang, M.Sc (Tech.)
Vishal Kumar, M.Pharm (Pharmacology)
Wali Inam, M.Sc. (Drug Discovery & Development)
Wenhui Zhou, M.Med.
Wu Yang, M.Med. (Clinical Medicine)
Xiang Lin, M.Sc. (Biotechnology)
Xiaodong Ma, M.Sc. (Organic Chemistry)
Xin Yang, M.Sc. (Pharm.Eng.)
Xiwen Geng, M.Sc. (Pathogen Biology)
Yonghui Wang, M. Sc. (Pharm, Cell Biology)
Yu Chen, M.Med. (Surgery)
Yu Zhang, M.Sc. (Med.)
Yuanyuan Jiang,M. Sc. (Pharm.)
Yuchen Su
Yuhehui Xiao, M.Sc. (Pharm.Sci.)